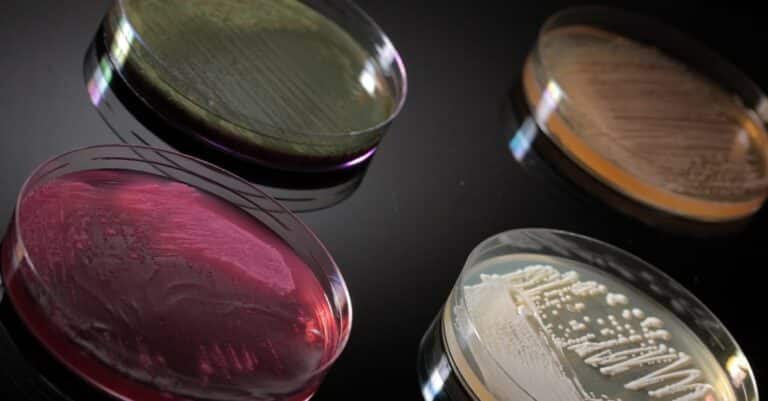

Our Products
We believe in science through the responsible and sustainable processes of fermentation and biocatalysis to provide products and solutions made from the highest quality sources provided by nature.

MenaQ7® Matrix
Vitamin K2 : The clinically proven health benefits of MenaQ7® delivered via an award-winning Vitamin K2 Mat...

Emothion®
Glutathione: The crystalline form of S-Acetyl Glutathione (GSH) is a powerful antioxidant that can help promote skin he...

LANDKIND® Pure Salidroside
Salidroside: Our innovative fermentation process bypasses the need to harvest the endangered Rhodiola rosea prod...

MenaQ7® Palm-Free MCT Oil
Vitamin K2 : For oil-based, sustainable, and palm-free finished product formulations, MenaQ7® Palm-Free MCT...

Adonat® Tablets
SAMe (S-adenosyl-L-methionine): We offer an exclusive and wide range of SAMe tablets available in two different proprie...

Adonat® Preformulated Bulk Powders
SAMe (S-adenosyl-L-methionine): We offer unique and flexible stabilized forms (powder and granules) suitable to be form...

Quatrefolic® PRO
Folate: An advanced form of active folate, specially designed to remain stable and effective in harsh conditions, like ...

Quatrefolic®
Folate: An innovative dietary ingredient designed to act as a nutrient in all areas where folic acid and folate supplem...

MenaQ7®
Vitamin K2: MenaQ7® is the optimal bioavailable 99.8% all-trans vitamin K2 as MK-7, produced in the ...

Extrafolate-S®
Folate: Calcium salt of (6S)-5-methyltetrahydrofolate intended for use as an alternative to folic acid in dietary suppl...

Extrafolate-S® Crystal
Folate: Extrafolate-S® Crystal is a new Gnosis ingredient with improved specifications: higher purity and s...

MyCondro™
Chondroitin sulfate: A fermentation-derived form of chondroitin sulfate, an ingredient linked with superior joint healt...

Lynside® Forte Zn
A nutritional yeast that is fortified with zinc, a nutrient linked with immunity and skin, hair, and nail health. In addition to zinc, this fortified yeast also provides vitam...

Lynside® Forte Se +
An organically bound nutritional yeast that is fortified with selenium, a nutrient linked with immunity and fertility. In addition to selenium, this fortified yeast also provi...

Quatreflora™
Probiotic Yeast: A new probiotic approach for women’s intimate health concerns, produced from a patented strain of

Lynside® Prebiotic Yeast
Prebiotic Yeast: The first patented yeast cell wall with a proven prebiotic effect. It promotes a balanced gut microbio...

Lynside® S. boulardii
Probiotic Yeast: Doctors and gastroenterologists know its high efficacy and prescribe it for decades to reduce occasion...

ibSium®
Probiotic Yeast: ibSium® (Saccharomyces cerevisiae CNCM I-3856) is a probiotic yeast clinically prov...

LifeinU® L.rhamnosus GG
Probiotic Bacteria: Lactobacillus rhamnosus GG (ATCC 53103) is one of the most studied and best-known probiotic ...

Red Star®
For more than 100 years, Red Star® has been renowned for its complete nutritional profile, which includes proteins, ß-glucans, vitamins, and minerals.

Lynside® Forte B
An organically bound nutritional yeast that is fortified with selenium, a nutrient linked with immunity and fertility. In addition to selenium, this fortified yeast also provi...

Adonat®
SAMe (S-adenosyl-L-methionine): The leading brand of S-Adenosyl-L-methionine (SAMe), a compound produced naturally by t...

Quatrefolic® Fine Powder
Folate: Quatrefolic® Fine Powder is the new versatile form of folate, a new physical form with a finer and ...

Lynside® Nutritional Yeasts
Our range of nutritional yeasts can be used in various applications such as dietary supplements, seasonings, and functional foods.

Noochy Crisp™
The first crispy nutritional yeast, the innovative and new form to revolutionize the market. With Noochy Crisp™, consumers will discover a sensorial experience thanks to an ...









